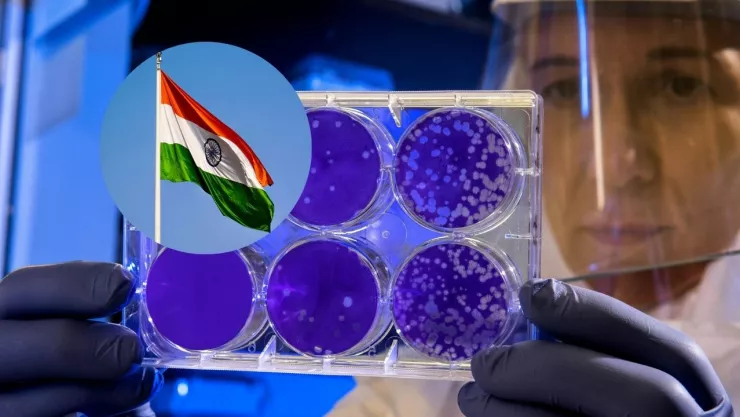
chandipura-virus-india-que-es

En India, las autoridades han intensificado las acciones de vigilancia después de que el virus Chandipura dejara un saldo de decenas de personas muertas el último mes.
Esta enfermedad es típica de varias partes del país asiático durante la temporada de monzones, pero muchas de las muertes en el estado de Gujarat fueron causadas debido a este patógeno, el cual suele afectar en su mayoría a menores de 15 años de edad.
¿Qué es el virus Chandipura?
El virus Chandipura debe su nombre a una pequeña comunidad en el estado de Maharashtra, que es donde fue descubierto. Este causa encefalitis (es decir, inflamación en el cerebro) en casos esporádicos.
*Stay Vigilant Against Chandipura Virus!*
— Yogsevak Sheeshpal ( Modi Ka Parivar) (@Sheeshpal_Yog) August 5, 2024
Symptoms: The infection typically begins with symptoms such as fever, headache, and muscle pain, which can progress to encephalitis, characterized by seizures, confusion, and sometimes coma.
Transmission: It is primarily transmitted by… pic.twitter.com/hgASNN7Ouq
Los síntomas son de fiebre y causa que el cerebro se inflame. Entre 1964 y 1965, la enfermedad fue descubierta debido a una epidemia de dengue y chikungunya. Para 1980, el virus fue aislado de pacientes que tenían encefalopatía.
Actualmente no existe un tratamiento estándar o algún antiviral para combatir el patógeno, debido a la poca información que hay sobre el virus, destaca el portal especializado The Conversation.
¿Cómo se propaga el virus Chandipura?
El virus Chandipura es propagado por un insecto llamado mosca de arena, así como por piquetes de garrapatas. Para ello, las autoridades sanitarias han realizado fumigaciones para evitar la reproducción de dichos animales.
“Hemos realizado fumigaciones en toda esta zona, hemos realizado fumigaciones residuales en interiores y también colocando medicamentos en lugares donde se almacena agua. (...) Además, hemos vertido MLO (aceite larvicida para mosquitos) en zanjas de agua que se habían contaminado para evitar la reproducción de la mosca de arena”, aseveró Kailash Dhak, subinspector de la corporación municipal de Ahmedabad, a la agencia de noticias Reuters.
Según el Comisionado de Salud de Gujarat, Harshad Patel, de los 56 muertos durante el último mes, se confirmó que una cuarta parte murió a causa del virus de Chandipura.